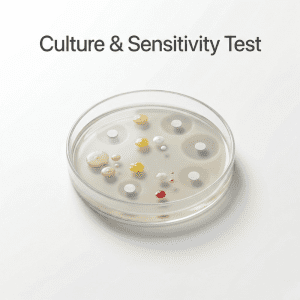

Culture & Sensitivity Test in Kanjurmarg: Fastest, Accurate & Affordable Diagnostic Guide
When you suffer from persistent infections, wound discharge, urinary symptoms, or fever, your physician may recommend a Culture & Sensitivity test in Kanjurmarg. This specialized lab test helps identify the exact microorganism (like bacteria or fungi) causing the infection and determines which antibiotics are most effective to treat it. With rising antibiotic resistance, getting an accurate culture & sensitivity report is more important than ever.
When you suffer from persistent infections, wound discharge, urinary symptoms, or fever, your physician may recommend a Culture & Sensitivity test in Kanjurmarg. This specialized lab test helps identify the exact microorganism (like bacteria or fungi) causing the infection and determines which antibiotics are most effective to treat it. With rising antibiotic resistance, getting an accurate culture & sensitivity report is more important than ever.
In this comprehensive guide, we’ll cover what the test is, why it’s essential, how it’s done, where to get it in Kanjurmarg, preparation, cost, result interpretation, and answers to commonly asked questions.
What Is a Culture & Sensitivity Test?
A Culture & Sensitivity test is a microbiological examination of body samples (like urine, blood, throat swab, wound swab, sputum) that helps:
- Culture: Grow the microorganism responsible for the infection.
- Sensitivity: Check which antibiotics the organism is sensitive or resistant to.
This helps doctors prescribe the most effective antibiotic — avoiding guesswork and reducing the risk of drug resistance.
Why Do You Need a Culture & Sensitivity Test?
Here are common reasons doctors recommend this test:
- Persistent or recurring infections
- Symptoms not responding to standard antibiotics
- Severe infections (like sepsis, pneumonia, UTI)
- Pre-surgical screening
- Monitoring chronic conditions (e.g., diabetic foot infections)
- Detecting hospital-acquired infections
Early diagnosis leads to faster recovery and prevents complications.
Types of Samples Used
Depending on the infection type, labs may culture different specimens:
- Urine
- Blood
- Sputum (for respiratory infections)
- Throat swab
- Wound swab
- Cerebrospinal fluid
- Other body fluids
The sample is incubated in a controlled environment so germs can grow and be tested.
How Is the Test Done?
- Sample Collection: A trained lab technician collects the specimen using sterile techniques.
- Culture Phase: The sample is placed on special media where bacteria or fungi grow.
- Identification: After growth, the organism is identified using biochemical methods.
- Sensitivity Testing: The culture is exposed to various antibiotics to see which one stops growth.
The final culture & sensitivity report helps doctors choose the most effective treatment.
Benefits of Culture & Sensitivity Test
- Accurate identification of infection source
- Personalized antibiotic therapy
- Reduces unnecessary antibiotic usage
- Helps prevent antibiotic resistance
- Faster recovery and fewer complications
This is why getting the test done from a reliable lab is essential.
Best Labs for Culture & Sensitivity Test in Kanjurmarg
Kanjurmarg hosts several reputed diagnostic centers and microbiology labs offering culture & sensitivity testing with swift turnaround times. When choosing a lab, consider Fastest Heath:
- Accreditation and quality standards
- Experienced lab technicians
- Fast reporting and easy appointment booking
- Home sample collection
- Reasonable price packages
Preparation Before the Test
Preparation depends on the sample type:
- Urine Test: Clean catch method — wash hands and genital area
- Throat Swab: Avoid eating or gargling 30 minutes prior
- Sputum Sample: Do not brush teeth before collection
- Blood Culture: Follow fasting instructions if required
Your lab or doctor will tell you exactly how to prepare.
Understanding Your Report
A typical culture & sensitivity report includes:
- Organism Isolated – the name of bacteria or fungus
- Antibiotic Sensitivity – antibiotics that work
- Antibiotic Resistance – antibiotics that won’t work
- MIC Values – exact concentration where the antibiotic is effective
A “sensitive” result means the bacteria can be killed or inhibited by that drug — this is usually recommended for treatment. “Resistant” means it won’t work and should not be used.
Turnaround Time With Fastest Health
Most labs deliver results within:
⏱ 24–48 hours for bacteria
⏱ 48–72 hours for slow-growing organisms
⏱ Sometimes 5–7 days for complex cultures
Faster results help doctors start targeted treatment sooner.
Tips to Get Accurate Results
- Ensure proper sample collection
- Avoid antibiotics right before sampling (only if your doctor approves)
- Transport the sample quickly
- Choose accredited labs with quality standards
These steps help reduce false-negative or contaminated results.
What is the main purpose of a culture & sensitivity test?
It identifies the infection-causing microorganism and determines which antibiotics will effectively treat it.
How fast can I get results in Kanjurmarg?
Fastest Health deliver results within 72 hours, but complex cases may take longer.
Is the test painful?
Most sample collections are non-invasive (urine, swabs). Blood culture may cause mild discomfort like any blood draw.
Can I do this test without a doctor’s referral?
Yes, many labs allow direct testing, but a doctor’s interpretation helps you understand results properly.
Is this test expensive in Kanjurmarg?
Prices vary depending on lab and sample type, but affordable options are available in the area.
Do I need to stop antibiotics before giving the sample?
Consult your doctor—stopping antibiotics without guidance may be harmful.